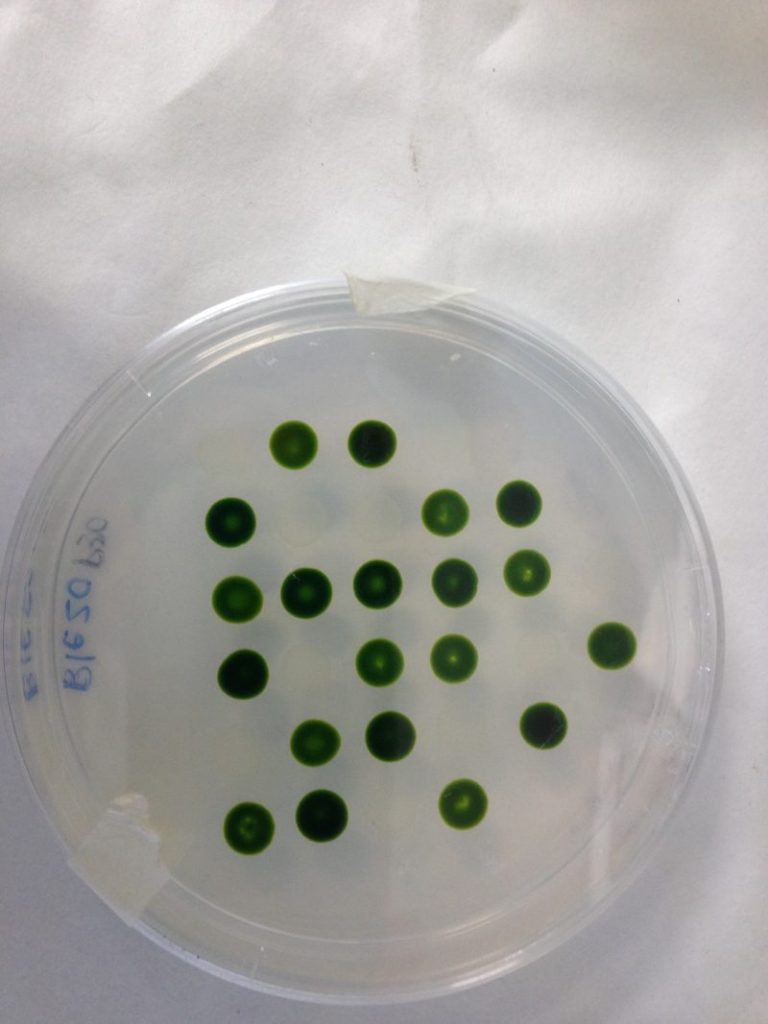

Investigadores de la Universidad de Huelva han duplicado la velocidad de producción de estos microorganismos con el uso de desechos de la industria vinícola. Además, han aumentado la eficiencia y reducido los costes para la producción de carburantes sostenibles a partir de estos organismos.
Autoría: Remedios Valseca / Fundación Descubre
Desde hace décadas, científicos e industrias de distintas áreas trabajan para conseguir combustibles sostenibles más económicos que los usados hasta el momento. Los enfoques de investigación son múltiples, pero todos persiguen un mismo objetivo: contaminar menos y que sean más asequibles para el consumidor final.
En esta línea, los investigadores de las Universidades de Huelva y del Algarve de Portugal han combinado el uso de microalgas y la reutilización de residuos para la producción de biodiésel más barato y mejorar la economía general del proceso al promover la economía circular. En un artículo que han publicado en la revista New Biotechnology, han demostrado que los residuos agroindustriales, lejos de ser un problema, pueden convertirse en un recurso para el cultivo de microorganismos de interés en el desarrollo de nuevos biocombustibles logrando duplicar la producción de microalgas con restos de la industria del vino.
Según indican los expertos, la tendencia por el biocombustible producido a partir de microalgas ha ido en aumento en los últimos años, ya que tienen un gran rendimiento y, dependiendo de la variedad, pueden acumular hasta un 60% de su peso en aceites que se pueden transformar en biocarburantes. Sin embargo, los costes siguen siendo demasiado altos para poder competir con los combustibles fósiles tradicionales.
Durante la investigación, se han utilizado con éxito diferentes desechos de la industria como fuente de carbono, incluido el extracto de vaina de algarroba, el glicerol procedente de biodiésel y las lías de vino oxidadas. “Este material procede de la parte sólida que queda en el depósito o la barrica después de la fermentación. Los resultados de nuestra investigación demuestran que, una vez oxidado, es el alimento ideal para que la Chlorella sorokiniana, crezca más y produzca más biomasa. Esta microalga tiene un alto potencial biotecnológico por su capacidad de sintetizar ácidos grasos de interés industrial”, indica a la Fundación Descubre la investigadora de la Universidad de Huelva Rosa León, autora del artículo.
Los expertos han incrementado el crecimiento de los microorganismos aprovechando la diversidad de su alimentación, ya que las microalgas son capaces de nutrirse de manera, autótrofa, usando dióxido de carbono y luz solar como las plantas, o de manera heterótrofa , a partir de bacterias u otras fuentes de carbono orgánico. Con la combinación de ambas, logran eliminar el problema de la falta de alimento en las zonas de sombra de los tanques donde se crían. Al mismo tiempo, por medio de un sistema de alimentación, llamado por lotes, logran cosechar mayor cantidad de la biomasa que producen de una manera más efectiva y rápida. Consiste en la aportación puntual de la fuente de carbono, en los tanques y cuando se observa que el crecimiento de la microalga se detiene, se cosecha la biomasa creada.
Sin embargo, para lograr una producción económicamente factible, es necesario elegir una fuente de carbono orgánico barata. Los expertos han evaluado la microalga Chlorella sorokiniana bajo diferentes condiciones de alimentación con las tradicionales fuentes de carbono de mayor coste, como glucosa o sacarosa, y fuentes alternativas de carbono de bajo costo, procedentes de residuos de la algarroba, de las lías de vino o el biodiésel, ricos en acetato y glicerol. Aprovechando la asimilación simultánea de dióxido de carbono de la fotosíntesis y fuentes de carbono orgánico, las microalgas producen biomasa de manera continuada porque nunca les falta el alimento.
De todos los alimentos, el que mejor resultados ha ofrecido ha sido el basado en las lías del vino oxidadas, con el que han logrado duplicar el crecimiento de la microalga y, por tanto, la producción de biomasa para la creación de biocombustibles.
De esta manera, los expertos contribuyen a la promoción de la economía circular, uno de los hitos marcados en la Estrategia Andaluza ante el Cambio Climático. Se trata de reincorporar al ecosistema, de la manera más fluida posible, los desechos que se producen en el mismo. Siguiendo la regla de las tres ‘R’ (reducir, reciclar, reutilizar), esta estrategia pretende que el actual flujo de los materiales (recursos-producto-residuos) se transforme en un flujo circular (recurso-producto-residuos reciclados-producto).
Más información en #CienciaDirecta: Duplican la velocidad de crecimiento de microalgas con residuos del vino para obtener biocombustible
